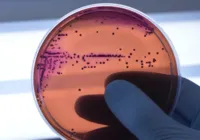
Salmonella: conheça bactéria que 'barrou' marca popular de bala

SAÚDE
Salmonella: conheça bactéria que 'barrou' marca popular de bala
Anvisa notifica e Dori recolhe balas de iogurte, morango e hortelã por risco de salmonella

SAÚDE
Anvisa proíbe venda de balas da marca Dori por suspeita de salmonella
Decisão foi publicada no Diário Oficial da União desta terça-feira, 20

BRASIL
Suspeita de salmonella é identificada em lotes da Ferrero
Um outro alerta sobre chocolates do grupo italiano foi dado há algumas semanas
Mais Lidas

ENTRETENIMENTO
Helen Ganzarolli revela queixa de fotógrafo da Playboy: Parece virgem

BAHIA
Festival Vermelho: Ato internacional reforça apoio à Palestina

ESPORTES
Clube tradicional da Série B é processado por padaria por pães

IMOBILIÁRIO
Juros altos travam sonho da casa própria

 OUÇA A RÁDIO
OUÇA A RÁDIO
